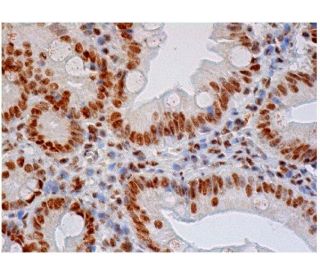
immunohistochemistry image from recommended hnRNP F/H (1G11) monoclonal antibody replacement. Image 284776

Informacoes sobre ordens
hnRNP F/H (1G11): sc-32310 [ anticorpo monoclonal substituto recomendado para hnRNP H (N-16) ]
| Nome do Produto | Numero de Catalogo | UNID | Preco | Qde | FAVORITOS | |
hnRNP F/H Anticorpo (1G11) | sc-32310 | 200 µg/ml | $322.00 | |||
Pacote do hnRNP F/H (1G11): m-IgGλ BP-HRP | sc-520839 | 200 µg Ab, 40 µg BP | $361.00 | |||
hnRNP F/H Anticorpo (1G11) AC | sc-32310 AC | 500 µg/ml, 25% agarose | $424.00 | |||
hnRNP F/H Anticorpo (1G11) HRP | sc-32310 HRP | 200 µg/ml | $322.00 | |||
hnRNP F/H Anticorpo (1G11) FITC | sc-32310 FITC | 200 µg/ml | $336.00 | |||
hnRNP F/H Anticorpo (1G11) PE | sc-32310 PE | 200 µg/ml | $349.00 | |||
hnRNP F/H Anticorpo (1G11) Alexa Fluor® 488 | sc-32310 AF488 | 200 µg/ml | $364.00 | |||
hnRNP F/H Anticorpo (1G11) Alexa Fluor® 546 | sc-32310 AF546 | 200 µg/ml | $364.00 | |||
hnRNP F/H Anticorpo (1G11) Alexa Fluor® 594 | sc-32310 AF594 | 200 µg/ml | $364.00 | |||
hnRNP F/H Anticorpo (1G11) Alexa Fluor® 647 | sc-32310 AF647 | 200 µg/ml | $364.00 | |||
hnRNP F/H Anticorpo (1G11) Alexa Fluor® 680 | sc-32310 AF680 | 200 µg/ml | $364.00 | |||
hnRNP F/H Anticorpo (1G11) Alexa Fluor® 790 | sc-32310 AF790 | 200 µg/ml | $364.00 |